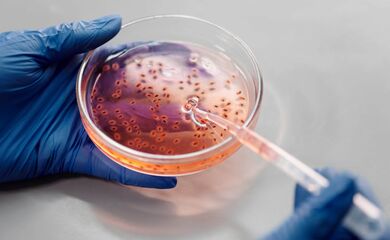

Analytical studies
Besides the clinical studies listed on the homepage, antigen rapid diagnostic tests (Ag-RDTs) are also evaluated in specific laboratory settings. In addition to sensitivity and specificity, such analytical studies analyze the lowest virus concentration an Ag-RDT is able to detect (Limit of Detection, LOD) and whether it incorrectly recognizes any pathogens other than SARS-CoV-2 (cross reactivity). In the following, we would like to give an overview of the results of analytical studies evaluating Ag-RDTs.
| Manufacturer, Test | Study location | Cross reactivity | LOD [log10 copies/swab] | LOD [viral load in pfu/ml] | LOD [log10 pfu/ml] | LOD [Ct-value] | LOD [viral load in RNA copies/ml] | LOD [log GE/test] | Source |
| Abbott, Panbio | Germany | - RSV-A | 6,551 | n/a | n/a | n/a | n/a | n/a | Corman, V.M., et al. |
| Germany | n/a | 6,07 | n/a | n/a | n/a | n/a | n/a | Haage, V., et al. | |
| Hong Kong | n/a | n/a | n/a | n/a | 26,29 | n/a | n/a | Mak, G.C.K., et al. | |
| England | n/a | n/a | 5.0 * 10^3 | n/a | n/a | n/a | n/a | Cubas-Atienzar, A.I., et al. | |
| Germany | n/a | n/a | n/a | n/a | n/a | 9.8*10^5 | n/a | Jungnick, S., et al. | |
| Germany | n/a | n/a | n/a | n/a | n/a | 8.5*10^5 based on B.1.351 variant | n/a | Jungnick, S., et al. | |
| Germany | n/a | n/a | n/a | n/a | n/a | 8.9*10^5 based on B.1.1.7 variant | n/a | Jungnick, S., et al. | |
| United Kingdom | n/a | n/a | n/a | n/a | n/a | n/a | 6,26 based on B.1.1.7 variant | Rodgers, M.A., et al. | |
| United Kingdom | n/a | n/a | n/a | n/a | n/a | n/a | 5,66-5,93 based on B.1.351 variant | Rodgers, M.A., et al. | |
| United Kingdom | n/a | n/a | n/a | n/a | n/a | n/a | 5,56 based on P.1 variant | Rodgers, M.A., et al. | |
| Switzerland | n/a | n/a | n/a | 3,63 based on B.1.610 variant | n/a | n/a | n/a | Beklitz, M., et al. | |
| Switzerland | n/a | n/a | n/a | 3,03 based on B.1.1.7 variant | n/a | n/a | n/a | Beklitz, M., et al. | |
| Switzerland | n/a | n/a | n/a | 3,03 based on B.1.351 variant | n/a | n/a | n/a | Beklitz, M., et al. | |
| Switzerland | n/a | n/a | n/a | 2,43 based on P.2 variant | n/a | n/a | n/a | Beklitz, M., et al. | |
| Switzerland | n/a | n/a | n/a | 2,43 based on P.1 variant | n/a | n/a | n/a | Beklitz, M., et al. | |
| unclear | n/a | n/a | 5*10^1 based on B.1.1.7 variant | n/a | n/a | n/a | n/a | Kontogianni, K., et al. | |
| Abbott, BinaxNOW | Germany | n/a | 4,6 - 4,92 | n/a | n/a | n/a | n/a | n/a | Perchetti. G.A., et al. |
| United Kingdom | n/a | n/a | n/a | n/a | n/a | n/a | 6,26 based on B.1.1.7 variant | Rodgers, M.A., et al. | |
| United Kingdom | n/a | n/a | n/a | n/a | n/a | n/a | 4,66 - 5,93 based on B.1.351 variant | Rodgers, M.A., et al. | |
| United Kingdom | n/a | n/a | n/a | n/a | n/a | n/a | 5,56 based on P.1 variant | Rodgers, M.A., et al. | |
| BIONOTE, NowCheck | Germany | n/a | 6,0 | n/a | n/a | n/a | n/a | n/a | Haage, V., et al. |
| England | n/a | n/a | 5.0 * 10^3 | n/a | n/a | n/a | n/a | Cubas-Atienzar, A.I., et al. | |
| Switzerland | n/a | n/a | n/a | 3,63 based on B.1.610 variant | n/a | n/a | n/a | Beklitz, M., et al. | |
| Switzerland | n/a | n/a | n/a | 3,03 based on B.1.1.7 variant | n/a | n/a | n/a | Beklitz, M., et al. | |
| Switzerland | n/a | n/a | n/a | 3,03 based on B.1.351 variant | n/a | n/a | n/a | Beklitz, M., et al. | |
| Switzerland | n/a | n/a | n/a | 2,73 based on P.2 variant | n/a | n/a | n/a | Beklitz, M., et al. | |
| Switzerland | n/a | n/a | n/a | 2,13 based on P.1 variant | n/a | n/a | n/a | Beklitz, M., et al. | |
| unclear | n/a | n/a | 5*10^2 based on B.1.1.7 variant | n/a | n/a | n/a | n/a | Kontogianni, K., et al. | |
| Boditech Med, ichroma | Germany | n/a | 5,91 | n/a | n/a | n/a | n/a | n/a | Haage, V., et al. |
| England | n/a | n/a | 1.0 * 10^4 | n/a | n/a | n/a | n/a | Cubas-Atienzar, A.I., et al. | |
| Coris BioConcept, Respi-Strip | Germany | none detected | 7,461 | n/a | n/a | n/a | n/a | n/a | Corman, V.M., et al. |
| Germany | n/a | 7,90 | n/a | n/a | n/a | n/a | n/a | Haage, V., et al. | |
| Hong Kong | n/a | n/a | n/a | n/a | 18,44 | n/a | n/a | Mak, G.C.K., et al. | |
| England | n/a | n/a | 5.0 * 10^3 | n/a | n/a | n/a | n/a | Cubas-Atienzar, A.I., et al. | |
| unclear | n/a | n/a | 1*10^3 based on B.1.1.7 variant | n/a | n/a | n/a | n/a | Kontogianni, K., et al. | |
| Edinburgh Genetics, ActivXpress | Germany | n/a | 6,15 | n/a | n/a | n/a | n/a | n/a | Haage, V., et al. |
| England | n/a | n/a | 1.0 * 10^4 | n/a | n/a | n/a | n/a | Cubas-Atienzar, A.I., et al. | |
| Switzerland | n/a | n/a | n/a | 3,93 based on B.1.610 variant | n/a | n/a | n/a | Beklitz, M., et al. | |
| Switzerland | n/a | n/a | n/a | 3,63 based on B.1.1.7 variant | n/a | n/a | n/a | Beklitz, M., et al. | |
| Switzerland | n/a | n/a | n/a | 3,63 based on B.1.351 variant | n/a | n/a | n/a | Beklitz, M., et al. | |
| Switzerland | n/a | n/a | n/a | 3,03 based on P.2 variant | n/a | n/a | n/a | Beklitz, M., et al. | |
| Switzerland | n/a | n/a | n/a | 2,43 based on P.1 variant | n/a | n/a | n/a | Beklitz, M., et al. | |
| unclear | n/a | n/a | 5*10^2 based on B.1.1.7 variant | n/a | n/a | n/a | n/a | Kontogianni, K., et al. | |
| Excalibur Healthcare Services, Rapid SARS-CoV-2 Antigen test card | England | n/a | n/a | 1.0 * 10^3 | n/a | n/a | n/a | n/a | Cubas-Atienzar, A.I., et al. |
| unclear | n/a | n/a | 5*10^2 based on B.1.1.7 variant | n/a | n/a | n/a | n/a | Kontogianni, K., et al. | |
| Fujirebio, ESPLINE® SARS-CoV-2 | England | n/a | n/a | 5.0 * 10^2 | n/a | n/a | n/a | n/a | Cubas-Atienzar, A.I., et al. |
| unclear | n/a | n/a | 2,5*10^2 based on B.1.1.7 variant | n/a | n/a | n/a | n/a | Kontogianni, K., et al. | |
| Guangzhou Wondfo Biotech, 2019-nCoV Antigen Test | England | n/a | n/a | 2.5 * 10^3 | n/a | n/a | n/a | n/a | Cubas-Atienzar, A.I., et al. |
| Switzerland | n/a | n/a | n/a | 3,63 based on B.1.610 variant | n/a | n/a | n/a | Beklitz, M., et al. | |
| Switzerland | n/a | n/a | n/a | 3,33 based on B.1.1.7 variant | n/a | n/a | n/a | Beklitz, M., et al. | |
| Switzerland | n/a | n/a | n/a | 3,63 based on B.1.351 variant | n/a | n/a | n/a | Beklitz, M., et al. | |
| Switzerland | n/a | n/a | n/a | 3,03 based on P.2 variant | n/a | n/a | n/a | Beklitz, M., et al. | |
| Switzerland | n/a | n/a | n/a | 2,43 based on P.1 variant | n/a | n/a | n/a | Beklitz, M., et al. | |
| unclear | n/a | n/a | 1*10^3 based on B.1.1.7 variant | n/a | n/a | n/a | n/a | Kontogianni, K., et al. | |
| Green Cross Medical Science, Genedia W COVID-19 Ag | Germany | n/a | 7,66 | n/a | n/a | n/a | n/a | n/a | Haage, V., et al. |
| England | n/a | n/a | 2.5 * 10^4 | n/a | n/a | n/a | n/a | Cubas-Atienzar, A.I., et al. | |
| Switzerland | n/a | n/a | n/a | 4,54 based on B.1.610 variant | n/a | n/a | n/a | Beklitz, M., et al. | |
| Switzerland | n/a | n/a | n/a | 4,24 based on B.1.1.7 variant | n/a | n/a | n/a | Beklitz, M., et al. | |
| Switzerland | n/a | n/a | n/a | 3,93 based on B.1.351 variant | n/a | n/a | n/a | Beklitz, M., et al. | |
| Switzerland | n/a | n/a | n/a | 3,33 based on P.2 variant | n/a | n/a | n/a | Beklitz, M., et al. | |
| Switzerland | n/a | n/a | n/a | 3,03 based on P.1 variant | n/a | n/a | n/a | Beklitz, M., et al. | |
| unclear | n/a | n/a | 5*10^2 based on B.1.1.7 variant | n/a | n/a | n/a | n/a | Kontogianni, K., et al. | |
| Healgen, Rapid Test | Germany | - Adenovirus - Entero / Rhinovirus - Influenzavirus A H1 - Influenzavirus A H3 - Parainfluenzavirus 1 - Parainfluenzavirus 2 - Parainfluenzavirus 3 | 6,371 | n/a | n/a | n/a | n/a | n/a | Corman, V.M., et al. |
| ichroma, COVID-19 AG | Switzerland | n/a | n/a | n/a | 3,33 based on B.1.610 variant | n/a | n/a | n/a | Beklitz, M., et al. |
| Switzerland | n/a | n/a | n/a | 3,03 based on B.1.1.7 variant | n/a | n/a | n/a | Beklitz, M., et al. | |
| Switzerland | n/a | n/a | n/a | 3,03 based on B.1.351 variant | n/a | n/a | n/a | Beklitz, M., et al. | |
| Switzerland | n/a | n/a | n/a | 2,13 based on P.2 variant | n/a | n/a | n/a | Beklitz, M., et al. | |
| Switzerland | n/a | n/a | n/a | 2,13 based on P.1 variant | n/a | n/a | n/a | Beklitz, M., et al. | |
| unclear | n/a | n/a | 2,5*10^2 based on B.1.1.7 variant | n/a | n/a | n/a | n/a | Kontogianni, K., et al. | |
| Innova Medical Group, INNOVA SARS-CoV-2 Antigen Rapid Qualitative Test | England | n/a | n/a | 1.0 * 10^3 | n/a | n/a | n/a | n/a | Cubas-Atienzar, A.I., et al. |
| unclear | n/a | n/a | 2,5*10^2 based on B.1.1.7 variant | n/a | n/a | n/a | n/a | Kontogianni, K., et al. | |
| JOYSBIO (Tianjin), COVID-19 Ag-RTK | Germany | n/a | 6,15 | n/a | n/a | n/a | n/a | n/a | Haage, V., et al. |
| England | n/a | n/a | 2.5 * 10^5 | n/a | n/a | n/a | n/a | Cubas-Atienzar, A.I., et al. | |
| Switzerland | n/a | n/a | n/a | 4,24 based on B.1.610 variant | n/a | n/a | n/a | Beklitz, M., et al. | |
| Switzerland | n/a | n/a | n/a | 4,54 based on B.1.1.7 variant | n/a | n/a | n/a | Beklitz, M., et al. | |
| Switzerland | n/a | n/a | n/a | 4,24 based on B.1.351 variant | n/a | n/a | n/a | Beklitz, M., et al. | |
| Switzerland | n/a | n/a | n/a | 2,73 based on P.2 variant | n/a | n/a | n/a | Beklitz, M., et al. | |
| Switzerland | n/a | n/a | n/a | 2,73 based on P.1 variant | n/a | n/a | n/a | Beklitz, M., et al. | |
| unclear | n/a | n/a | 1*10^2 based on B.1.1.7 variant | n/a | n/a | n/a | n/a | Kontogianni, K., et al. | |
| Mologic, Mologic COVID-19 Ag Test device | England | n/a | n/a | 2.5 * 10^2 | n/a | n/a | n/a | n/a | Cubas-Atienzar, A.I., et al. |
| unclear | n/a | n/a | 2,5*10^2 based on B.1.1.7 variant | n/a | n/a | n/a | n/a | Kontogianni, K., et al. | |
| NAL von minden, NADAL | Germany | none detected | 6,971 | n/a | n/a | n/a | n/a | n/a | Corman, V.M., et al. |
| Hong Kong | n/a | n/a | n/a | n/a | 18,44 | n/a | n/a | Mak, G.C.K., et al. | |
| Germany | n/a | n/a | n/a | n/a | n/a | 9.8*10^5 | n/a | Jungnick, S., et al. | |
| Germany | n/a | n/a | n/a | n/a | n/a | 8.5*10^5 based on B.1.351 variant | n/a | Jungnick, S., et al. | |
| Germany | n/a | n/a | n/a | n/a | n/a | 8.9*10^5 based on B.1.1.7 variant | n/a | Jungnick, S., et al. | |
| Premier Medical Corporation, Sure Status COVID-19 Antigen Card Test | England | n/a | n/a | 5.0 * 10^2 | n/a | n/a | n/a | n/a | Cubas-Atienzar, A.I., et al. |
| Switzerland | n/a | n/a | n/a | 2,43 based on B.1.610 variant | n/a | n/a | n/a | Beklitz, M., et al. | |
| Switzerland | n/a | n/a | n/a | 2,43 based on B.1.1.7 variant | n/a | n/a | n/a | Beklitz, M., et al. | |
| Switzerland | n/a | n/a | n/a | 2,43 based on B.1.351 variant | n/a | n/a | n/a | Beklitz, M., et al. | |
| Switzerland | n/a | n/a | n/a | 2,43 based on P.2 variant | n/a | n/a | n/a | Beklitz, M., et al. | |
| Switzerland | n/a | n/a | n/a | 2,43 based on P.1 variant | n/a | n/a | n/a | Beklitz, M., et al. | |
| unclear | n/a | n/a | 5*10^1 based on B.1.1.7 variant | n/a | n/a | n/a | n/a | Kontogianni, K., et al. | |
| RapiGEN, Biocredit | Germany | none detected | 10,21 | n/a | n/a | n/a | n/a | n/a | Corman, V.M., et al. |
| Hong Kong | n/a | n/a | n/a | n/a | 18,44 | n/a | n/a | Mak, G.C.K., et al. | |
| England | n/a | n/a | 5.0 * 10^4 | n/a | n/a | n/a | n/a | Cubas-Atienzar, A.I., et al. | |
| Germany | n/a | n/a | 6.8*10^3 | n/a | n/a | n/a | n/a | FINDdx | |
| Germany | n/a | n/a | n/a | n/a | n/a | 3.1*10^7 | n/a | Jungnick, S., et al. | |
| Germany | n/a | n/a | n/a | n/a | n/a | 2.6*10^5 based on B.1.351 variant | n/a | Jungnick, S., et al. | |
| Germany | n/a | n/a | n/a | n/a | n/a | 3.4*10^5 based on B.1.1.7 variant | n/a | Jungnick, S., et al. | |
| unclear | n/a | n/a | 5*10^4 based on B.1.1.7 variant | n/a | n/a | n/a | n/a | Kontogianni, K., et al. | |
| R-Biopharm, RIDA QUICK | Germany | - Influenzavirus A H1 - Influenzavirus A H3 | 6,321 | n/a | n/a | n/a | n/a | n/a | Corman, V.M., et al. |
| Roche, SARS-CoV-2 Rapid Antigen Test | Germany | n/a | n/a | n/a | n/a | n/a | 9.8*10^5 | n/a | Jungnick, S., et al. |
| Germany | n/a | n/a | n/a | n/a | n/a | 8.5*10^5 based on B.1.351 variant | n/a | Jungnick, S., et al. | |
| Germany | n/a | n/a | n/a | n/a | n/a | 8.9*10^5 based on B.1.1.7 variant | n/a | Jungnick, S., et al. | |
| unclear | n/a | n/a | 2,5*10^2 based on B.1.1.7 variant | n/a | n/a | n/a | n/a | Kontogianni, K., et al. | |
| SD Biosensor / Roche, Standard F | England | n/a | n/a | 2.5 * 10^4 | n/a | n/a | n/a | n/a | Cubas-Atienzar, A.I., et al. |
| unclear | n/a | n/a | 1*10^2 based on B.1.1.7 variant | n/a | n/a | n/a | n/a | Kontogianni, K., et al. | |
| SD Biosensor / Roche, Standard Q | Germany | - Parainfluenzavirus 3 | 6,781 | n/a | n/a | n/a | n/a | n/a | Corman, V.M., et al. |
| Germany | n/a | 6,0 | n/a | n/a | n/a | n/a | n/a | Haage, V., et al. | |
| Hong Kong | n/a | n/a | n/a | n/a | 28,67 | n/a | n/a | Mak, G.C.K., et al. | |
| Hong Kong | n/a | n/a | n/a | n/a | 26,29 | n/a | n/a | Mak, G.C.K., et al. | |
| England | n/a | n/a | 5.0 * 10^3 | n/a | n/a | n/a | n/a | Cubas-Atienzar, A.I., et al. | |
| Switzerland | n/a | n/a | n/a | 3,03 based on B.1.610 variant | n/a | n/a | n/a | Beklitz, M., et al. | |
| Switzerland | n/a | n/a | n/a | 2,73 based on B.1.1.7 variant | n/a | n/a | n/a | Beklitz, M., et al. | |
| Switzerland | n/a | n/a | n/a | 3,03 based on B.1.351 variant | n/a | n/a | n/a | Beklitz, M., et al. | |
| Switzerland | n/a | n/a | n/a | 2,73 based on P.2 variant | n/a | n/a | n/a | Beklitz, M., et al. | |
| Switzerland | n/a | n/a | n/a | 2,43 based on P.1 variant | n/a | n/a | n/a | Beklitz, M., et al. | |
| unclear | n/a | n/a | 2,5*10^2 based on B.1.1.7 variant | n/a | n/a | n/a | n/a | Kontogianni, K., et al. | |
| Shenzen Bioeasy, FIA | Germany | n/a | 6,85 | n/a | n/a | n/a | n/a | n/a | Haage, V., et al. |
| England | n/a | n/a | 5.0 * 10^3 | n/a | n/a | n/a | n/a | Cubas-Atienzar, A.I., et al. | |
| Siemens Healthineers, CLINITEST | Germany | n/a | 6,04 | n/a | n/a | n/a | n/a | n/a | Haage, V., et al. |
| Germany | n/a | n/a | n/a | n/a | n/a | 1.7*10^5 | n/a | Jungnick, S., et al. | |
| Germany | n/a | n/a | n/a | n/a | n/a | 8.5*10^5 based on B.1.351 variant | n/a | Jungnick, S., et al. | |
| Germany | n/a | n/a | n/a | n/a | n/a | 8.9*10^5 based on B.1.1.7 variant | n/a | Jungnick, S., et al. | |
| Zhejiang Orient Gene Biotech, Coronavirus Ag Rapid Test | England | n/a | n/a | 2.5 * 10^3 | n/a | n/a | n/a | n/a | Cubas-Atienzar, A.I., et al. |
1 At the given LOD, the authors accepted a 5% false-negative rate. Thus, the true LOD could vary slightly.
2 The authors allowed no false-negatives. Only a LOD-range could be provided as the estimation of virus concentration of the test specimen was done using two different PCR methods. The true value lies in between.